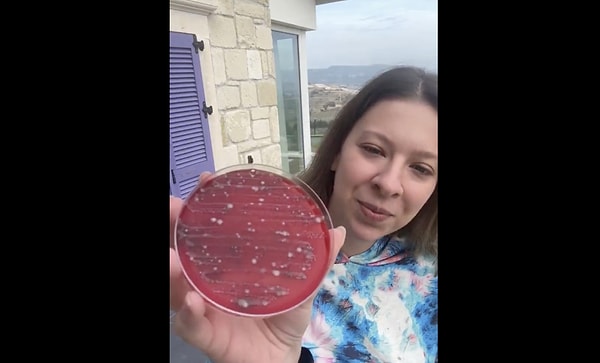
En temiz ağız kedinin!

Genetik Mühendisi Dilara Sarı'nın yaptığı birbirinden ilginç deneylere daha önce mutlaka denk gelmişsinizdir. Kendisi erkek sakalından havlulara kadar pek çok yüzeyin bakteri üretme oranını gösteren deneyler yaptı ve birçok kişiyi bu konuda aydınlattı. Dilara Sarı yine çok merak edilen bir konuyu ele aldı ve yine ilginç bir deneye imza attı.
Sarı hem kendi ağzından hem bir kedinin hem de bir köpeğin ağzından aldığı örnekleri besiyerine ekti ve 3 gün sonunda sonuçları karşılaştırdı. Çıkan sonuç pek çok kişiyi şaşırttı.
Buradan izleyebilirsiniz;
En temiz ağız kedinin!
Deney sonucunda kedinin ağzından alınan örneklerde herhangi bir bakteri üremesi olmazken, en çok bakteri üremesi köpeğin ağzından alınan örneğin ekildiği besiyerinde gerçekleşti. Bu sonuç en çok da kedisi olduğu için, evlerinde yemek yemek istenmeyen kedi sahiplerini mutlu etti.
👇




Keşfet ile ziyaret ettiğin tüm kategorileri tek akışta gör!





Yorum Yazın